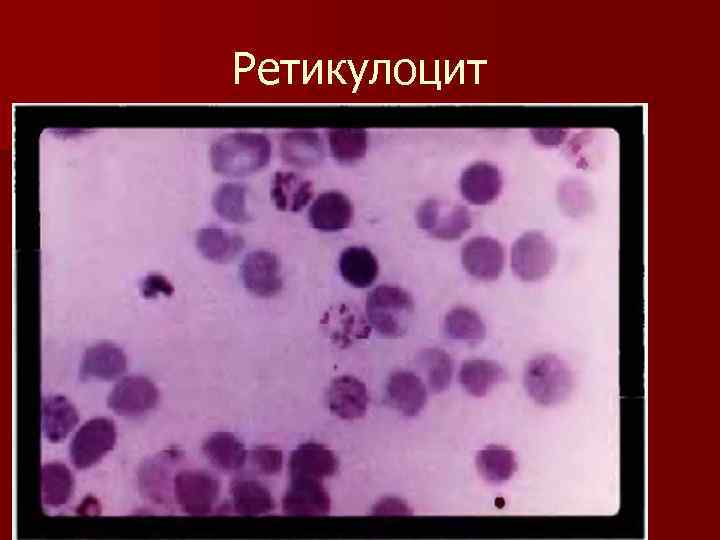
Ретикулоцит
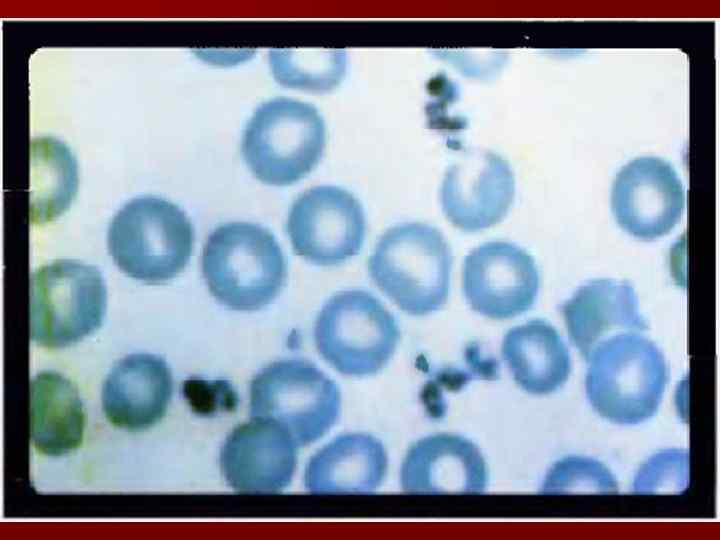

Виды гемоглобина, гемолиз.ppt
- Количество слайдов: 54

 n Эритроцит- двояковогнутый диск, круглые и овальные клетки, n диаметр – 0, 007 мм, n толщина – 0, 002 мм.
n Эритроцит- двояковогнутый диск, круглые и овальные клетки, n диаметр – 0, 007 мм, n толщина – 0, 002 мм.
 n. В норме 1 л крови эритроцитов содержится 4, 5 -5, 0 х 1012 (4, 5 -5, 5 х 1012 у мужчин, 4, 0 -5, 1 х 1012 /л у женщин), что объясняется действием половых гормонов. (эритроцитоз, эритремия) возникает при гипоксии, мышечной работе. n Повышение n Понижение (эритропения, анемия) при избытке воды, усиленном гемолизе.
n. В норме 1 л крови эритроцитов содержится 4, 5 -5, 0 х 1012 (4, 5 -5, 5 х 1012 у мужчин, 4, 0 -5, 1 х 1012 /л у женщин), что объясняется действием половых гормонов. (эритроцитоз, эритремия) возникает при гипоксии, мышечной работе. n Повышение n Понижение (эритропения, анемия) при избытке воды, усиленном гемолизе.
 n n n n Функции эритроцитов 1) дыхательная — перенос кислорода от альвеол легких к тканям и углекислого газа от тканей к легким; 2) регуляция р. Н крови благодаря одной из мощнейших буферных систем крови — гемоглобиновой; 3) питательная — перенос на своей поверхности аминокислот от органов пищеварения к клеткам организма; 4) защитная — адсорбция на своей поверхности токсических веществ; 5) участие в процессе свертывания крови за счет содержания факторов свертывающей и противосвертывающей систем крови; 6) эритроциты являются носителями разнообразных ферментов (холинэстераза, угольная ангидраза, фосфатаза) и витаминов (В 1, В 2, В 6, аскорбиновая кислота); 7) эритроциты несут в себе групповые признаки крови.
n n n n Функции эритроцитов 1) дыхательная — перенос кислорода от альвеол легких к тканям и углекислого газа от тканей к легким; 2) регуляция р. Н крови благодаря одной из мощнейших буферных систем крови — гемоглобиновой; 3) питательная — перенос на своей поверхности аминокислот от органов пищеварения к клеткам организма; 4) защитная — адсорбция на своей поверхности токсических веществ; 5) участие в процессе свертывания крови за счет содержания факторов свертывающей и противосвертывающей систем крови; 6) эритроциты являются носителями разнообразных ферментов (холинэстераза, угольная ангидраза, фосфатаза) и витаминов (В 1, В 2, В 6, аскорбиновая кислота); 7) эритроциты несут в себе групповые признаки крови.
 n. В норме различают 2 группы эрироцитов. n 1. Регенеративная (от слова регенерация) или восстановлен. n 2. Дегенеративная.
n. В норме различают 2 группы эрироцитов. n 1. Регенеративная (от слова регенерация) или восстановлен. n 2. Дегенеративная.
 1. Регенеративная форма. n Ретикулоцит – молодая клетка, предстадия зрелого эритроцита. В норме на 1000 эритроцитов приходится от 2 до 10 ретикулоцитов (2 -10 0 промили). n Отличительная черта – сетчатонитчатая субстанция. Для ее выявления используется прежизненная окраска – окрашен в сине-зеленый цвет. n Нормобласты – в зависимости от окраски, т. е. накопление гемоглобина.
1. Регенеративная форма. n Ретикулоцит – молодая клетка, предстадия зрелого эритроцита. В норме на 1000 эритроцитов приходится от 2 до 10 ретикулоцитов (2 -10 0 промили). n Отличительная черта – сетчатонитчатая субстанция. Для ее выявления используется прежизненная окраска – окрашен в сине-зеленый цвет. n Нормобласты – в зависимости от окраски, т. е. накопление гемоглобина.
Ретикулоцит
Ретикулоцит
 2. Дегенеративные формы. n 1. n– Анизоцитоз клетки различного диаметра. Нормоциты, микроциты (<6, 5 мкм) и макроциты (>8 мкм), мегалоциты (>12 мкм).
2. Дегенеративные формы. n 1. n– Анизоцитоз клетки различного диаметра. Нормоциты, микроциты (<6, 5 мкм) и макроциты (>8 мкм), мегалоциты (>12 мкм).

 Макроциты, мегалоциты и дегенеративные формы при гипопластической анемии.
Макроциты, мегалоциты и дегенеративные формы при гипопластической анемии.
 2. n Пойкилоцитоз – эритроциты различной формы. Основная форма – несколько овальная с просветвлением в центре.
2. n Пойкилоцитоз – эритроциты различной формы. Основная форма – несколько овальная с просветвлением в центре.
 А) в виде серпа при серповидной анемии.
А) в виде серпа при серповидной анемии.
 Б) шизоциты – с неровными краями
Б) шизоциты – с неровными краями
 n В) клетки с утолщением в центре
n В) клетки с утолщением в центре
 3. Анизохромия – эритроциты с различной степенью окраски (выделяют нормохромию 0, 8 – 1 у. е. , гипохромию< 0, 8 уе и гиперхромию>1 уе)
3. Анизохромия – эритроциты с различной степенью окраски (выделяют нормохромию 0, 8 – 1 у. е. , гипохромию< 0, 8 уе и гиперхромию>1 уе)
 n Объективным оценочным критерием данного состояния является расчет цветного показателя (или называется цветовой показатель) n Цветовой показатель (ЦП)– средняя степень насыщения каждого эритроцита гемоглобином. n В норме ЦП = 0, 85 – 1, 0 у. ед. содержание гемоглобина 140 -160 г/л
n Объективным оценочным критерием данного состояния является расчет цветного показателя (или называется цветовой показатель) n Цветовой показатель (ЦП)– средняя степень насыщения каждого эритроцита гемоглобином. n В норме ЦП = 0, 85 – 1, 0 у. ед. содержание гемоглобина 140 -160 г/л
 n Разрушаются эритроциты за счет внутрисосудистого гемолиза
n Разрушаются эритроциты за счет внутрисосудистого гемолиза
 Основные виды гемолиза эритроцитов. n Все они связаны с изменением резистентности эритроцитов — их способности противостоять разрушительным воздействиям. n Продукты гемолиза адсорбируются клетками печени, селезенки, лимфоузлов и некоторых других органов.
Основные виды гемолиза эритроцитов. n Все они связаны с изменением резистентности эритроцитов — их способности противостоять разрушительным воздействиям. n Продукты гемолиза адсорбируются клетками печени, селезенки, лимфоузлов и некоторых других органов.
 1. Осмотический гемолиз - разрыв оболочки эритроцита и выход гемоглобина в плазму крови n возникает в гипотоническом растворе. Эритроциты набухают, а при значительном набухании разрушаются; кровь становится прозрачной «лаковая» кровь). n Мин. осмотическая резистентность: 0, 48 -0, 42 % Na. Cl n Макс. осмотическая резистентность: 0, 34 -0, 30% Na. Cl
1. Осмотический гемолиз - разрыв оболочки эритроцита и выход гемоглобина в плазму крови n возникает в гипотоническом растворе. Эритроциты набухают, а при значительном набухании разрушаются; кровь становится прозрачной «лаковая» кровь). n Мин. осмотическая резистентность: 0, 48 -0, 42 % Na. Cl n Макс. осмотическая резистентность: 0, 34 -0, 30% Na. Cl
 Осмотические свойства крови Изотония Na. Cl 0, 5% вода Na. Cl 0, 95% Гипертония Na. Cl 0, 95% Гипотония Na. Cl 0, 95% Осмотическое давление крови – 7, 5 атм. Na. Cl вода 2, 0%
Осмотические свойства крови Изотония Na. Cl 0, 5% вода Na. Cl 0, 95% Гипертония Na. Cl 0, 95% Гипотония Na. Cl 0, 95% Осмотическое давление крови – 7, 5 атм. Na. Cl вода 2, 0%
 2. Механический гемолиз
2. Механический гемолиз
 3. Биологический
3. Биологический
 4. Химический
4. Химический
 5. Термический гемолиз возникает при неправильном хранении крови
5. Термический гемолиз возникает при неправильном хранении крови
 6. Внутриклеточный
6. Внутриклеточный
 Стареющие эритроциты удаляются из циркулирующей крови. Разрушаются в селезенке, печени и немного в костном мозге клетками системы фагоцитирующих мононуклеотидов. Фракции Jg. G сыворотки содержат аутоантитела против старых эритроцитов, прикрепление которых к эритроцитам приводит к фагоцитозу.
Стареющие эритроциты удаляются из циркулирующей крови. Разрушаются в селезенке, печени и немного в костном мозге клетками системы фагоцитирующих мононуклеотидов. Фракции Jg. G сыворотки содержат аутоантитела против старых эритроцитов, прикрепление которых к эритроцитам приводит к фагоцитозу.
 Эритроцит состоит из тонкой сетчатой стромы, ячейки которой заполнены пигментом гемоглобином и более плотной оболочки.
Эритроцит состоит из тонкой сетчатой стромы, ячейки которой заполнены пигментом гемоглобином и более плотной оболочки.
 Красный цвет крови обусловлен наличием в эритроцитах гемоглобина.
Красный цвет крови обусловлен наличием в эритроцитах гемоглобина.

 ГЕМОГЛОБИН — особый белок хромопротеида, благодаря которому эритроциты выполняют дыхательную функцию и поддерживоют р. Н крови. n. У мужчин в крови содержится в среднем -160 г/л гемоглобина, n у женщин — 120— 150 г/л.
ГЕМОГЛОБИН — особый белок хромопротеида, благодаря которому эритроциты выполняют дыхательную функцию и поддерживоют р. Н крови. n. У мужчин в крови содержится в среднем -160 г/л гемоглобина, n у женщин — 120— 150 г/л.
 n Гемоглобин состоит из 2 -х частей – белка глобина и 4 молекул гема. Гем включает 2 -х валентное железо, и способен присоединять или отдавать молекулу кислорода. При этом валентность железа, к которому присоединяется кислород, не изменяется, т. е. железо остается двухвалентным.
n Гемоглобин состоит из 2 -х частей – белка глобина и 4 молекул гема. Гем включает 2 -х валентное железо, и способен присоединять или отдавать молекулу кислорода. При этом валентность железа, к которому присоединяется кислород, не изменяется, т. е. железо остается двухвалентным.
 Строение гемоглобина
Строение гемоглобина
 n. В норме – 1 г гемоглобина может связывать 1, 34 мл О 2. Это называется кислородной ёмкостью крови.
n. В норме – 1 г гемоглобина может связывать 1, 34 мл О 2. Это называется кислородной ёмкостью крови.
 Соединения гемоглобина. n А) nс физиологические О 2 – (К+Hb. О 2) – оксигемоглобин n с СО 2 - (Н+Hb. CO 2) – карбогемоглобин n H + Hb – восстановленный гемоглобин
Соединения гемоглобина. n А) nс физиологические О 2 – (К+Hb. О 2) – оксигемоглобин n с СО 2 - (Н+Hb. CO 2) – карбогемоглобин n H + Hb – восстановленный гемоглобин
 n Б) патологические n- с угарным газом -(Н+Hb. CO) – карбоксигемоглобин, устойчивый; n- в присутствии сильных окислителей (КMn. О 4, бертолетовой соли) – 2 -х валентное Fе превращается в 3 -х валентное с образованием стойкого соединения не распадающегося в тканях → удушье
n Б) патологические n- с угарным газом -(Н+Hb. CO) – карбоксигемоглобин, устойчивый; n- в присутствии сильных окислителей (КMn. О 4, бертолетовой соли) – 2 -х валентное Fе превращается в 3 -х валентное с образованием стойкого соединения не распадающегося в тканях → удушье
 Виды (формы) гемоглобина. n отличаются строением белковой части — глобина, что определяет сродство гемоглобина к О 2.
Виды (формы) гемоглобина. n отличаются строением белковой части — глобина, что определяет сродство гемоглобина к О 2.
 1) Р – примитивный n Hb. Р – он обладает большим сродством к кислороду и появляется у эмбриона человека на 7 -12 неделе развития.
1) Р – примитивный n Hb. Р – он обладает большим сродством к кислороду и появляется у эмбриона человека на 7 -12 неделе развития.
 2) Фетальный n Hb. F – к 9 -ой неделе развития появляется гемоглобин который заменяет примитивный Hb к моменту рождения.
2) Фетальный n Hb. F – к 9 -ой неделе развития появляется гемоглобин который заменяет примитивный Hb к моменту рождения.
 В течение первого года жизни ребенка фетальный гемоглобин постепенно заменяется на гемолобин А.
В течение первого года жизни ребенка фетальный гемоглобин постепенно заменяется на гемолобин А.
 3) Гемолобин А – гемоглобин взрослого Hb. А (и А 2 – 2 -3%).
3) Гемолобин А – гемоглобин взрослого Hb. А (и А 2 – 2 -3%).
 Миоглобин n. В скелетных и сердечной мышцах находится мышечный гемоглобин. Он играет важную роль в снабжении кислородом работающих мышц.
Миоглобин n. В скелетных и сердечной мышцах находится мышечный гемоглобин. Он играет важную роль в снабжении кислородом работающих мышц.

 n Для образования гемоглобина (Нb) в организм с пищей должно поступать Fе и витамин В 12. Много Fе: в мясе, печени, яйцах, изюме, яблоках, черносливе.
n Для образования гемоглобина (Нb) в организм с пищей должно поступать Fе и витамин В 12. Много Fе: в мясе, печени, яйцах, изюме, яблоках, черносливе.
 Физиология эритропоэза
Физиология эритропоэза
 Эритроциты неоднородны, различаются по возрасту, форме, размеру, устойчивости к неблагоприятным факторам. В периферической крови одновременно находятся молодые, зрелые и старые эритроциты. Молодые эритроциты в цитоплазме имеют включения – остатки ядерной субстанции и называются ретикулоцитами.
Эритроциты неоднородны, различаются по возрасту, форме, размеру, устойчивости к неблагоприятным факторам. В периферической крови одновременно находятся молодые, зрелые и старые эритроциты. Молодые эритроциты в цитоплазме имеют включения – остатки ядерной субстанции и называются ретикулоцитами.
 n. В норме со дня рождения и до глубокой старости нормобластический тип кроветворения с прохождением стадии ретикулоцита. И в норме встречаются различные нормы эритроцитов.
n. В норме со дня рождения и до глубокой старости нормобластический тип кроветворения с прохождением стадии ретикулоцита. И в норме встречаются различные нормы эритроцитов.

 n– Тромбоциты это кровяные пластинки, безъядерные, бесцветные клетки 2 -4 мкм. n Образуются в красном костном мозге. Очень хрупкие, легко разрушаются при повреждении сосудов. При этом выделяют вещество тромбопластин, участвующий в свертывании крови.
n– Тромбоциты это кровяные пластинки, безъядерные, бесцветные клетки 2 -4 мкм. n Образуются в красном костном мозге. Очень хрупкие, легко разрушаются при повреждении сосудов. При этом выделяют вещество тромбопластин, участвующий в свертывании крови.
 n Количество тромбоцитов в норме 180, 0 -320, 0 х109/л. n Уменьшение количества тромбоцитов (тромбоцитопения) наблюдается при болезни Верльгофа, лейкозах, некоторых видах отравлений. n Увеличение количества тромбоцитов (тромбоцитоз) отмечается при кровопотерях, после удалении селезёнки и при некоторых формах злокачественных новообразований.
n Количество тромбоцитов в норме 180, 0 -320, 0 х109/л. n Уменьшение количества тромбоцитов (тромбоцитопения) наблюдается при болезни Верльгофа, лейкозах, некоторых видах отравлений. n Увеличение количества тромбоцитов (тромбоцитоз) отмечается при кровопотерях, после удалении селезёнки и при некоторых формах злокачественных новообразований.
 n Образуются в красном костном мозге. Очень хрупкие, легко разрушаются при повреждении сосудов. При этом выделяют вещество тромбопластин, участвующий в свертывании крови. n Свойства: адгезия – склеивание и агрегация – скучивание – обеспечивают сосудисто-тромбоцитарный гемостаз.
n Образуются в красном костном мозге. Очень хрупкие, легко разрушаются при повреждении сосудов. При этом выделяют вещество тромбопластин, участвующий в свертывании крови. n Свойства: адгезия – склеивание и агрегация – скучивание – обеспечивают сосудисто-тромбоцитарный гемостаз.

Спасибо за внимание!
Спасибо за внимание!



